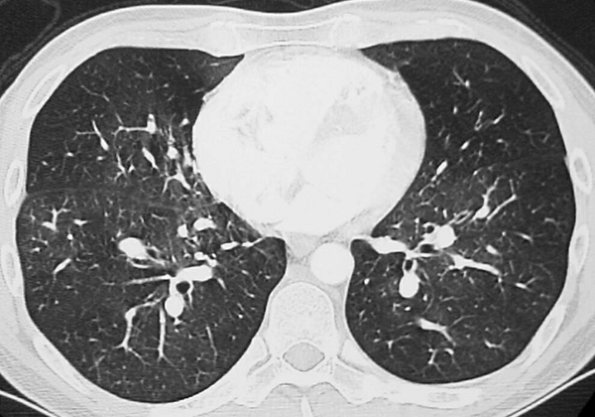

Chapter 17
Pulmonary Vasculature Disease
Learning Objectives
- Recognize central and subsegmental pulmonary emboli on chest computed tomography (CT).
- Define the role of ventilation-perfusion scintigraphy, CT pulmonary angiography, chest magnetic resonance imaging/magnetic resonance angiography, CT venography, and lower-extremity venous ultrasound studies in the evaluation of a patient with suspected venous thromboembolic disease, including the advantages and limitations of each modality depending on patient presentation.
- Recognize enlarged pulmonary arteries on a chest radiograph and distinguish them from enlarged hilar lymph nodes.
- Recognize enlargement of the central pulmonary arteries with diminution of the peripheral pulmonary arteries on a chest radiograph and suggest the diagnosis of pulmonary arterial hypertension.
- Name several causes of precapillary and postcapillary pulmonary arterial hypertension.
Pulmonary vascular disease is a relatively common cause
of chest pain and dyspnea. It can be acute, as in pulmonary embolism
(PE), or chronic, as in most cases of pulmonary arterial hypertension
(PAH). This chapter will review these two conditions and pulmonary
artery tumors. Pulmonary arteriovenous malformations are discussed in Chapter 16.
Pulmonary Thromboembolic Disease
PE is the third most common acute cardiovascular disease, after myocardial infarction and stroke (1).
However, there is considerable uncertainty and confusion with regard to
accurate diagnosis of this condition. The clinical signs and symptoms
associated with PE are nonspecific, as are laboratory investigations,
electrocardiograms, and chest radiographs. When PE occurs without
infarction, the chest radiograph may be normal, or it may show any or
all of the following: oligemia of the affected lung (the Westermark
sign; see Fig. 2-21), increase in the size of
the main pulmonary artery, elevation of the diaphragm, pleural effusion
(usually small and unilateral), or discoid atelectasis. The chest
radiograph is usually abnormal in patients with PE, however, with
nonspecific subsegmental atelectasis being the most common abnormal
finding (2). No chest radiographic sign is
specific for pulmonary embolism or infarction, and the sensitivity of
chest radiography for these conditions is poor. Even with a large
pulmonary artery clot burden, the chest radiograph can be normal (3).
The main role of the chest radiograph, therefore, is to exclude other
diagnoses that might mimic PE clinically, such as pneumonia or
pneumothorax. Because PE often goes undetected, the diagnosis of PE
should be considered in any patient who presents with acute shortness
of breath and pleuritic chest pain.
Deep venous thrombosis (DVT) originates most commonly in
lower-extremity or pelvic veins, where they dislodge and propagate
cranially into the pulmonary arterial tree. Radiologic studies used to
diagnose thromboembolic disease include chest radiography,
ventilation-perfusion (V/Q) scans, computed tomographic pulmonary
angiography (CTPA), magnetic resonance imaging/magnetic resonance
angiography (MRI/MRA), CT venography (CTV), MR venography, and
lower-extremity ultrasound. Once the gold standard for diagnosing PE,
catheter-based pulmonary angiography has largely been replaced by CTPA
and is now used mainly when the results of CTPA and V/Q scanning are
indeterminate and there is continued high clinical suspicion of PE. The
ideal test to diagnose PE should be accurate, direct (objective),
rapid, safe, readily available, and of reasonable cost. Because only
approximately 30% of patients with clinically suspected PE have the
disease (4), a diagnostic test that is able to
provide information regarding the presence and significance of other
chest disease would also be desirable. None of the common tests in use
(other than CTPA) meet all or even most of these criteria. V/Q
scintigraphy was the main imaging modality used in the evaluation of
patients with suspected PE until the advent of multidetector CT
scanning. A high-probability V/Q scan provides sufficient certainty to
confirm the diagnosis of PE, while a normal or near normal scan
reliably excludes the diagnosis. However, in the Prospective
Investigation of Pulmonary Embolism Diagnosis (PIOPED) study (4),
indeterminate scans, which were present in 364 (39%) of 931 patients,
showed a 30% incidence of PE, and low-probability scans (i.e., two
thirds of V/Q scans in the PIOPED study) were not useful in
establishing or excluding PE. In many institutions, CTPA has become the
test of choice rather than V/Q scintigraphy or catheter-based pulmonary
angiography. A suggested diagnostic algorithm for the evaluation of
suspected PE is described in Table 17-1.
Recent studies have found the sensitivity of
thin-section multidetector CTPA to be 96% to 100% and the specificity
to be 89% to 98% for the detection of pulmonary emboli to the level of
the subsegmental arteries (5,6).
Characteristic findings of acute PE are: (a) partial central filling
defect surrounded by a thin rim of contrast material, or (b) complete
filling defect with obstruction of an entire vessel section (“vessel
cutoff sign”) (Figs. 17-1, 17-2, 17-3, 17-4, 17-5). Pulmonary arteries that are completely obstructed by an acute embolus usually have an increased diameter (Figs. 17-6 and 17-7).
Arteries peripheral to a central thrombus may or may not opacify.
Central clot does not necessarily completely obstruct the distal flow
of contrast. Although nonocclusive clot is depicted by CTPA,
false-negative
scintigraphy in this setting is well known. Acute embolic obstruction of a large degree of the pulmonary circulation increases pulmonary vascular resistance, leading to acute PAH. CTPA findings suggesting this complication include right ventricular enlargement (right ventricle/left ventricle ratio >1) and straightening or leftward bowing of the interventricular septum (Fig. 17-8). Pitfalls to be aware of in diagnosing PE include lymph nodes; impacted bronchi (Figs. 17-9 and 17-10); respiratory motion; vessel bifurcation; unopacified pulmonary veins (Fig. 17-11); periarterial abnormalities (lymph node enlargement or infiltration of the axial interstitium by edema fluid, inflammation, or neoplasm); pulmonary artery catheters; and pulmonary artery sarcoma (7).
P.272
scintigraphy in this setting is well known. Acute embolic obstruction of a large degree of the pulmonary circulation increases pulmonary vascular resistance, leading to acute PAH. CTPA findings suggesting this complication include right ventricular enlargement (right ventricle/left ventricle ratio >1) and straightening or leftward bowing of the interventricular septum (Fig. 17-8). Pitfalls to be aware of in diagnosing PE include lymph nodes; impacted bronchi (Figs. 17-9 and 17-10); respiratory motion; vessel bifurcation; unopacified pulmonary veins (Fig. 17-11); periarterial abnormalities (lymph node enlargement or infiltration of the axial interstitium by edema fluid, inflammation, or neoplasm); pulmonary artery catheters; and pulmonary artery sarcoma (7).
 |
FIGURE 17-1. Incidental PE on CT. CT of a 70-year-old man with colon cancer shows intraluminal filling defect (arrow)
in the right upper lobe pulmonary artery. The study was performed to
assess for metastatic disease. Acute emboli are occasionally detected
incidentally on routine CT; such findings illustrate the importance of
evaluating the pulmonary arteries on all CT studies. |
 |
FIGURE 17-2. Acute PE.
Coronal CTPA of a 43-year-old man with acute shortness of breath shows
extensive intraluminal filling defect within the right lower lobe
pulmonary arteries (arrows). |
CTPA findings diagnostic of chronic PE include mural thrombus (adherent to the arterial wall), which may or may not be calcified (Fig. 17-12); webs; stenosis or strictures of the arteries (Fig. 17-13);
and a central "dot" of contrast surrounded by circumferential thrombus,
which is indicative of recanalization. Ancillary findings include
mosaic perfusion with decreased caliber of vessels in the
hypoattenuated areas of lung (Fig. 17-14), enlarged pulmonary arteries and right ventricle (Figs. 17-15 and 17-16), and enlarged bronchial arteries (Figs. 17-3 and 17-17).
CTPA, like conventional angiography, usually enables distinction
between acute and chronic PE; this is not possible with scintigraphy.
The clinical significance of small emboli is unclear,
but data suggest that small, untreated clots in patients without
impaired cardiopulmonary reserve may not be associated with poor
outcome (8). Several investigations have found that the negative predictive value of CTPA ≥97% (9),
suggesting that anticoagulants can be safely withheld when CTPA is
normal and of good diagnostic quality. In patients without concomitant
cardiopulmonary disease, no difference in the incidence of recurrent PE
between treated and untreated patients with small clots has been noted (10).
However, in patients with limited cardiopulmonary reserve, such small
emboli may be fatal. Isolated subsegmental clot on single-detector CT
is very unusual, and the risk of anticoagulation may exceed the risk of
morbidity and mortality from the suspected clot in this setting (11).
Major advantages of CTPA over V/Q scintigraphy to
investigate patients suspected of acute PE include (a) direct
visualization of emboli on CTPA; (b) evaluation of the lung parenchyma
and mediastinum, which may provide an alternate diagnosis; and (c)
capability of acquiring a CTV study without
additional contrast (Fig. 17-18). Investigators have shown that CTPA provides an alternative diagnosis (e.g., pneumonia, pneumothorax, pleural effusion, pericarditis, aortic dissection, aortic aneurysm, congestive heart failure, rib fracture, lung nodules or mass, mediastinal mass or air, gallstones, chronic obstructive pulmonary disease) in up to two thirds of patients with an initial suspicion of PE (8). Limitations of CTPA include patients with an allergy to contrast material, impaired renal function, the inability to lie supine, the inability to be transported to the CT scanner, or inadequate intravenous access. Other limitations of CTPA include motion artifact caused by inability of the patient to hold his or her breath or by adjacent cardiac motion, poor contrast bolus enhancement, image noise in large patients, partial volume averaging (Fig. 17-19), parenchymal disease, and streak artifact from lines and tubes or dense contrast material.
P.273
P.274
P.275
P.276
P.277
P.278
P.279
P.280
additional contrast (Fig. 17-18). Investigators have shown that CTPA provides an alternative diagnosis (e.g., pneumonia, pneumothorax, pleural effusion, pericarditis, aortic dissection, aortic aneurysm, congestive heart failure, rib fracture, lung nodules or mass, mediastinal mass or air, gallstones, chronic obstructive pulmonary disease) in up to two thirds of patients with an initial suspicion of PE (8). Limitations of CTPA include patients with an allergy to contrast material, impaired renal function, the inability to lie supine, the inability to be transported to the CT scanner, or inadequate intravenous access. Other limitations of CTPA include motion artifact caused by inability of the patient to hold his or her breath or by adjacent cardiac motion, poor contrast bolus enhancement, image noise in large patients, partial volume averaging (Fig. 17-19), parenchymal disease, and streak artifact from lines and tubes or dense contrast material.
 |
FIGURE 17-3. Acute PE. A:
CTPA of a 77-year-old man with shortness of breath shows an
intraluminal filling defect, surrounded by a rim of contrast, within
the right lower lobe segmental pulmonary arteries (arrow). B:
Coronal CTPA shows decreased caliber of arteries in the right lung
compared with the left and filling defect within right lower lobe
vessels. C: Catheter-based pulmonary angiogram confirms clot within right lower lobe vessels (arrows). |
 |
FIGURE 17-4. Acute PE. A:
CTPA of a 77-year-old woman with a gastrointestinal bleed and DVT shows
an intraluminal filling defect in a left lower lobe segmental pulmonary
artery (arrow). B:
CTPA at a more superior level shows intraluminal filling defects,
surrounded by contrast material, in the right middle lobe and left
lower lobe pulmonary arteries (arrows). C: CTPA at a level superior to (B)
shows an intraluminal filling defect, surrounded by a thin rim of
contrast material, in a right lower lobe segmental pulmonary artery (arrow). |
 |
FIGURE 17-5. Acute PE. A:
CTPA of a 78-year-old woman shows an intraluminal filling defect
surrounded by contrast material in the proximal right lower lobe
pulmonary artery (arrow). B:
Coronal CTPA shows that the intraluminal filling defect extends from
the proximal right lower lobe pulmonary artery inferiorly to distal
branches (arrows). C: CTPA with lung windowing shows oligemia and diminution of vessels on the right (Westermark sign). |
 |
FIGURE 17-6. Acute PE. A:
Posteroanterior (PA) chest radiograph of a 52-year-old woman with
cholangiocarcinoma shows a rounded opacity at the left costophrenic
angle, representing a Hampton hump of pulmonary infarction. B: CTPA shows a saddle embolus bridging the lingular and left lower lobe pulmonary arteries (arrow). C: CTPA at a more inferior level shows intraluminal filling defects expanding the proximal lower lobe pulmonary arteries (arrows). |
 |
FIGURE 17-7. Acute PE.
CTPA of a 76-year-old man with acute shortness of breath shows a large
intraluminal filling defect within the proximal right lower lobe
pulmonary artery (solid arrow) and a smaller intraluminal filling defect within a segmental pulmonary artery to the left lower lobe (dashed arrow). |
 |
FIGURE 17-8. Acute PE associated with pulmonary arterial hypertension. A:
CTPA of a 23-year-old man involved in a motor vehicle crash shows a
saddle embolus straddling the right and left main pulmonary arteries (arrows). The central pulmonary arteries are enlarged. B: CTPA at a more inferior level shows thrombus within segmental branches of the lower lobe pulmonary arteries (arrows). C: CTPA at a level inferior to (B) shows leftward bowing of the interventricular septum (arrow). |
 |
FIGURE 17-9. Mucous plugging. CTPA of a 75-year-old man with an esophageal stricture and gastroesophageal reflux shows a dilated esophagus (E) and low-attenuation material within the lower lobe segmental bronchi (arrows). The adjacent pulmonary vessels enhance normally. |
 |
FIGURE 17-10. Mucous plugging. A: CTPA shows low-attenuation material occluding the right lower lobe subsegmental bronchi (arrow). The adjacent pulmonary vessels enhance normally. B: Coronal CT shows the impacted right lower lobe bronchi (arrows) adjacent to normally enhancing pulmonary vessels. |
 |
FIGURE 17-11. Pulmonary vein. CTPA shows a nonenhancing pulmonary vein in the left lower lobe (arrow). This should not be confused with a pulmonary artery. Pulmonary veins can be traced back to the left atrium on serial images. |
 |
FIGURE 17-12. Acute and chronic PE. A:
Anteroposterior recumbent chest radiograph of a 27-year-old man with a
history of DVT and acute shortness of breath shows right upper lobe
airspace disease, mimicking pneumonia, and fullness of the left hilum,
mimicking adenopathy. Endotracheal tube is positioned slightly high (arrowhead). B: CTPA shows wedge-shaped, pleural-based airspace disease in the right upper and lower lobes. The main (M), right (R), and left lower lobe (L) pulmonary arteries are enlarged, correlating with the measured systolic pulmonary artery pressure of 90 mm Hg. C: CTPA at a level inferior to (B) shows old low-attenuation clot, eccentrically distributed along the posterior wall of the right pulmonary artery (arrowheads), and acute clot filling a right lower lobe basilar segmental pulmonary artery branch (arrow). |
 |
FIGURE 17-13. Chronic PE. A:
PA chest radiograph of a 43-year-old woman with recurrent DVT and PE
for 20 years shows a small right pulmonary artery and diminutive
vessels in the right upper lobe. B: CTPA shows a small irregular right pulmonary artery with residual clot and areas of recanalization (solid arrow) and bronchial artery collaterals (dashed arrow). C: CTPA at a more inferior level shows additional bronchial artery collaterals in a paraspinal and subpleural location (arrows). The main pulmonary artery (PA) is markedly enlarged. D: CTPA with lung windowing shows small right pulmonary arteries and a mosaic pattern of lung attenuation. |
|
FIGURE 17-14. Chronic PE. CTPA shows a mosaic pattern of lung attenuation. Note diminutive vessels in the areas of hypoattenuated lung. |
 |
FIGURE 17-15. Chronic PE. CTPA shows marked enlargement of the main pulmonary artery, which is larger in diameter than the adjacent ascending aorta. |
 |
FIGURE 17-16. Chronic PE. CTPA shows enlargement of the right ventricle (RV) and right atrium (RA). The right ventricle/left ventricle (LV) ratio is greater than 1. |
 |
FIGURE 17-17. Chronic PE. CTPA shows enlarged bronchial arteries (arrow) adjacent to the esophagus. |
 |
FIGURE 17-18. Deep venous thrombosis and acute PE. A: CTPA of a 66-year-old woman with an endometrial mass and left leg swelling shows bilateral PE. B: CTV performed immediately after the CTPA shows left DVT (arrow). C:
CTV at a more inferior level shows expansion of the involved left
lower-extremity vein and soft tissue stranding of the adjacent fat (arrow). |
PE and DVT are different manifestations of the same
clinical disease. One advantage of CTPA is the ability to add CTV, from
the iliac crest to the tibial plateau, to detect DVT in the legs
and pelvis (Figs. 17-20 and 17-21). Both CTPA and CTV can be accomplished with the same bolus of contrast agent. Unlike lower-extremity ultrasound, CTV can image the external and internal iliac veins. Venous thrombosis can also occur in the upper extremities and in the thorax and can be detected on CTPA (Fig. 17-22).
P.281
and pelvis (Figs. 17-20 and 17-21). Both CTPA and CTV can be accomplished with the same bolus of contrast agent. Unlike lower-extremity ultrasound, CTV can image the external and internal iliac veins. Venous thrombosis can also occur in the upper extremities and in the thorax and can be detected on CTPA (Fig. 17-22).
 |
FIGURE 17-19. Partial volume artifact. A: CT with 5-mm collimation shows incomplete enhancement of a left lower lobe segmental pulmonary artery (arrow). B: CTPA on the same day shows homogeneous enhancement of the vessel and no evidence of PE. |
The D-dimer assay, a test that detects one of the
products of fibrin breakdown in the blood, is an important rapid
initial test for DVT and PE. Recent studies show that the enzyme-linked
immunosorbent assay D-dimer test can accurately rule out DVT and PE in
the vast majority of cases (11). However, this
test can be falsely positive in postoperative patients, patients on
anticoagulation, and patients with recent trauma.
 |
FIGURE 17-20. Deep venous thrombosis. CTV shows intraluminal filling defect within the left femoral vein (arrow). |
MRI is useful in the evaluation of suspected PE when
patients are allergic to iodinated contrast medium. Because it does not
involve ionizing radiation, it is also advantageous in children and
pregnant women.
Anticoagulant therapy must be considered for DVT as well
as for PE; therefore, ultrasound of the deep venous system should have
a primary screening role in patients suspected of PE. Ultrasound
imaging has the advantages of being readily available and noninvasive.
If ultrasound is negative for DVT, depending on the degree of clinical
suspicion, further evaluation is generally obtained with a V/Q scan or
CTPA.
The diagnostic feature of PE on a V/Q scan is a
perfusion defect in a region of normally ventilated lung - the so-called
"mismatched perfusion defect." Interpretation of V/Q scans is based on
a comparison of the V/Q images and the chest radiograph, which gives
rise to a report of "normal" or of low, intermediate, or high
probability of PE (4). An abnormal V/Q scan
indicating a low probability for recent PE is one in which the
individual perfusion defects are smaller than 25% of a segment,
regardless of the chest radiographic and ventilation scan appearances;
are matched on the ventilation scan; or are accompanied by larger chest
radiographic abnormalities. A high-probability scan is one in which
there are two or more perfusion defects that are not matched by
corresponding ventilation defects or chest radiographic abnormalities,
including at least one of segmental or larger size. In the appropriate
clinical setting, a high-probability V/Q scan indicates a probability
of PE exceeding 90%. An intermediate-probability V/Q scan, also
described as an indeterminate scan, is an abnormal scan that does not
fit into the low- or high-probability categories. It includes those
with perfusion defects that, although matched, correspond in size and
shape to an area of opacity on the chest radiograph (and, therefore,
may represent infarction or pneumonia) or with perfusion defects in
areas of severe obstructive lung disease, pulmonary edema, or pleural
effusion.
P.282
 |
FIGURE 17-21. Deep venous thrombosis. A: CTV of a 42-year-old man with protein C deficiency and recurrent DVT shows a filling defect within a left pelvic vein (arrow). B: CTV at a more inferior level shows thrombus within the left femoral vein (arrow). |
Only 15% or fewer of thromboemboli cause pulmonary infarction (12).
It is not known why some emboli cause infarction and others do not, but
it is likely a result of compromise of both the pulmonary and bronchial
arterial circulation. This is most likely to occur with peripheral
emboli and in patients with left heart failure or circulatory shock (13). It is known that bronchial circulation alone can sustain the lung parenchyma without infarction occurring (14).
Pulmonary infarction results in airspace opacities that
are usually multifocal and predominantly in the lower lungs. They
usually appear within 12 to 24 hours after the embolic event. The
opacities are classically peripheral, with a triangular or rounded
shape (thus the term Hampton hump), and they are always in contact with the pleural surfaces (Figs. 17-23 and 17-24).
The apex of the opacity is directed toward the lung hilum.
Occasionally, lobar opacity resembling pneumonia can occur. Air
bronchograms are rarely present. It is important to note that the
opacities can represent a combination of pulmonary hemorrhage and
atelectasis without infarction, in which case clearing occurs within a
week. Infarction takes several months to resolve, often with residual
scarring (Fig. 17-25). As infarcts resolve, they melt away "like an ice cube" (giving rise
to the so-called "melting ice cube sign"; Fig. 2-16). The opacity clears from the periphery first, whereas in pneumonia the opacity clears homogeneously, both centrally and peripherally at the same time. Cavitation can occur within infarcts but is rare without coexisting infection, either secondary infection of an infarct or a result of septic emboli or vasculitis.
P.283
to the so-called "melting ice cube sign"; Fig. 2-16). The opacity clears from the periphery first, whereas in pneumonia the opacity clears homogeneously, both centrally and peripherally at the same time. Cavitation can occur within infarcts but is rare without coexisting infection, either secondary infection of an infarct or a result of septic emboli or vasculitis.
 |
FIGURE 17-22. Superior vena cava thrombus. A: CT of a 47-year-old woman on hemodialysis shows nearly complete occlusion of the superior vena cava with thrombus (arrow). B: CT at a more inferior level shows collateralization of blood flow through an enlarged right azygos vein (arrow). C: CT at a level inferior to (B) shows enlargement of the azygos (solid arrow) and hemiazygos (dashed arrow) veins. |
 |
FIGURE 17-23. Pulmonary infarction.
PA chest radiograph of a 68-year-old woman with acute shortness of
breath shows a pleural-based, rounded opacity at the right costophrenic
angle (Hampton hump; arrows), representing
an acute parenchymal infarct. There is elevation of the right
hemidiaphragm from atelectasis and subpulmonic effusion. |
Pulmonary Arterial Hypertension
PAH is defined as pulmonary artery pressures above the
normal systolic value of 30 mm Hg or above the mean value of 18 mm Hg.
There are numerous causes of PAH (Table 17-2),
which is classically categorized as either precapillary or
postcapillary. Regardless of the etiology, the radiologic features are
similar and include enlargement of the central pulmonary arteries and
narrowing or "pruning" of the peripheral pulmonary artery branches (Fig. 17-26). Right ventricular enlargement is often appreciated on the lateral chest radiograph. However,
substantial PAH may be present in patients with normal chest radiographs. CT more accurately depicts the size of the pulmonary arteries and cardiac chambers. As a general rule, PAH is present when the main pulmonary artery diameter exceeds that of the ascending aorta or is 29 mm or more in diameter (15) (Fig. 17-27). In long-standing and severe PAH, the enlarged central pulmonary arteries may develop thrombus and peripheral calcification. This is most often seen in patients with Eisenmenger physiology, a condition characterized by a reversal in the direction of a long-standing severe left-to-right shunt (i.e., atrial septal defect, ventricular septal defect, patent ductus arteriosus) (Fig. 17-28). In postcapillary and some precapillary disorders, changes of pulmonary venous hypertension may be seen. The most salient finding is cephalization of pulmonary vasculature, which represents recruitment of upper lobe vasculature secondary to a diversion of blood flow. Pericardial effusions, usually small to moderate in size, are commonly associated with PAH.
P.284
substantial PAH may be present in patients with normal chest radiographs. CT more accurately depicts the size of the pulmonary arteries and cardiac chambers. As a general rule, PAH is present when the main pulmonary artery diameter exceeds that of the ascending aorta or is 29 mm or more in diameter (15) (Fig. 17-27). In long-standing and severe PAH, the enlarged central pulmonary arteries may develop thrombus and peripheral calcification. This is most often seen in patients with Eisenmenger physiology, a condition characterized by a reversal in the direction of a long-standing severe left-to-right shunt (i.e., atrial septal defect, ventricular septal defect, patent ductus arteriosus) (Fig. 17-28). In postcapillary and some precapillary disorders, changes of pulmonary venous hypertension may be seen. The most salient finding is cephalization of pulmonary vasculature, which represents recruitment of upper lobe vasculature secondary to a diversion of blood flow. Pericardial effusions, usually small to moderate in size, are commonly associated with PAH.
 |
FIGURE 17-24. Bilateral pulmonary infarcts. CT shows bilateral pleural-based opacities characteristic of pulmonary infarcts. |
 |
FIGURE 17-25. Old pulmonary infarcts. CT shows bilateral subpleural linear opacities, representing scarring from previous pulmonary infarcts. |
TABLE 17-2 CAUSES OF PULMONARY ARTERIAL HYPERTENSION | |
|---|---|
|
 |
FIGURE 17-26. Primary pulmonary arterial hypertension. PA (A) and lateral (B)
chest radiographs of a 54-year-old woman, obtained as part of a workup
for lung transplantation, show enlargement of the central pulmonary
arteries and narrowing of the peripheral branches. Fine curvilinear
calcification can be seen outlining the central pulmonary arteries on
the lateral view (arrowheads). There is
also enlargement of the right atrium and right ventricle (note
increased opacity posterior to the sternum on the lateral view). |
 |
FIGURE 17-27. Primary pulmonary arterial hypertension. A: PA chest radiograph of a 54-year-old woman shows enlargement of the pulmonary arteries (arrows) and cardiac enlargement. B: CT confirms enlargement of the main (PA),
right, and left pulmonary arteries. Note that the main pulmonary artery
is larger in diameter than the adjacent ascending aorta. Systolic and
diastolic pulmonary artery pressures were 97 mm Hg and 53 mm Hg,
respectively, with a mean pressure of 70 mm Hg. C: CT at a more inferior level shows enlargement of the right atrium (RA) and right ventricle (RV). |
P.285
Pulmonary Artery Tumors
Primary pulmonary artery sarcomas are exceedingly rare.
They involve the central pulmonary arteries and often completely
occlude the involved vessel. The appearance on CT can mimic massive
acute PE. However, when complete occlusion and expansion
of the main, left, or right pulmonary arteries is seen, tumor should be
considered. Even so, it is more common that this appearance is caused
by metastatic tumor or invasion of the pulmonary artery by adjacent
mediastinal or central bronchogenic carcinoma than by primary pulmonary
artery sarcoma.
 |
FIGURE 17-28. Pulmonary arterial hypertension and Eisenmenger physiology. A:
PA chest radiograph of a 47-year-old woman with a long-standing atrial
septal defect shows enlargement of the pulmonary arteries (arrows) and cardiomegaly. B: Lateral view shows rim calcification of enlarged pulmonary arteries (arrows). |
Tumors most commonly known to embolize through the
pulmonary arterial circulation include bronchioloalveolar carcinoma;
carcinomas of the breast, kidney, stomach, liver, and prostate; and
choriocarcinoma (16). The characteristic CT features are dilatation and beading of peripheral pulmonary arteries
(Fig. 17-29). The appearance can resemble the "tree-in-bud" appearance of small airway disease (17). Maximum-intensity-projection images can be helpful in showing continuity of the distal vessels with more central pulmonary vessels in cases of tumor emboli. Many more cases of tumor emboli are discovered at autopsy than antemortem.
P.286
(Fig. 17-29). The appearance can resemble the "tree-in-bud" appearance of small airway disease (17). Maximum-intensity-projection images can be helpful in showing continuity of the distal vessels with more central pulmonary vessels in cases of tumor emboli. Many more cases of tumor emboli are discovered at autopsy than antemortem.
 |
FIGURE 17-29. Tumor emboli. A: CT of a 16-year-old boy with a large pelvic sarcoma shows dilated and beaded peripheral pulmonary arteries (arrows). B: Maximum-intensity-projection image shows the continuity of these abnormal vessels with the central pulmonary arteries. |
References
1. Horlander
KT, Mannino DM, Leeper KV. Pulmonary embolism mortality in the United
States, 1979–1998: an analysis using multiple-cause mortality data. Arch Intern Med. 2003;163:1711–1717.
2. Worsley
DF, Alari A, Aronchick JM, et al. Chest radiographic findings in
patients with acute pulmonary embolism: observations from the PIOPED
study. Radiology. 1993;189:133–136.
3. Wenger NK, Stein PD, Willis PW. Massive acute pulmonary embolism: the deceivingly nonspecific manifestations. JAMA. 1972;220:843–844.
4. The
PIOPED Investigators: value of ventilation-perfusion scan in acute
pulmonary embolism. Results of the prospective investigation of
pulmonary embolism diagnosis (PIOPED). JAMA. 1990;20(263):2753–2759.
5. Coche
E, Verschuren F, Keyeux A, et al. Diagnosis of acute pulmonary embolism
in outpatients: comparison of thin-collimation multi-detector row
spiral CT and planar ventilation-perfusion scintigraphy. Radiology. 2003;229:757–765.
6. Winer-Muram
HT, Rydberg J, Johnson MS, et al. Suspected acute pulmonary embolism:
evaluation with multi-detector row CT versus digital subtraction
pulmonary arteriography. Radiology. 2004;233:806–815.
7. Gotway MB, Yee J. Helical CT pulmonary angiography for acute pulmonary embolism. Appl Radiol. 2002;April:21–30.
8. Hull RD, Raskob GE, Ginsberg JS, et al. A noninvasive strategy for the treatment of patients with suspected pulmonary embolism. Arch Intern Med. 1994;154:289–297.
9. Kavanagh EC, O'Hare A, Hargaden G, et al. Risk of pulmonary embolism after negative MDCT pulmonary angiography findings. AJR Am J Roentgenol. 2004;182:499–504.
10. Stein PD, Henry JW, Relyea B. Untreated patients with pulmonary embolism: outcome, clinical, and laboratory assessment. Chest. 1995;107:931–935.
11. Perrier A, Roy PM, Sanchez O, et al. Multidetector-row computed tomography in suspected pulmonary embolism. N Engl J Med. 2005;352:1760–1768.
12. Moser KM. Pulmonary embolism: state of the art. Am Rev Respir Dis. 1977;115:829–852.
13. Tsao MS, Schraufnagel D, Wang NS. Pathogenesis of pulmonary infarction. Am J Med. 1982;72:599–606.
14. Dalen JE, Haffajee CI, Alpert JS, et al. Pulmonary embolism, pulmonary hemorrhage and pulmonary infarction. N Engl J Med. 1977;296:1431–1435.
15. Kuriyama K, Gamsu G, Stern RG, et al. CT-determined pulmonary artery diameters in predicting pulmonary hypertension. Invest Radiol. 1984;19:16–22.
16. Shepard
JO, Moore EH, Templeton PA, et al. Pulmonary intravascular tumor
emboli: dilated and beaded peripheral pulmonary arteries at CT. Radiology. 1993;187:797–801.
17. Franquet
T, Gimenez A, Prats R, et al. Thrombotic microangiopathy of pulmonary
tumors: a vascular cause of tree-in-bud pattern on CT. AJR Am J Roentgenol. 2002;179:897–899.